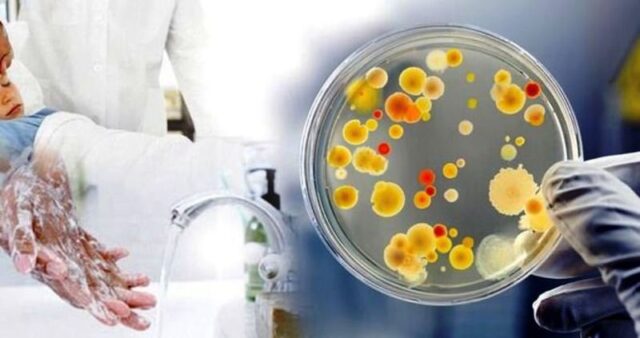

52 людини отруїлися на Житомирщині у минулому році в закладах громадського харчування. Також зафіксували 10 випадків побутового ботулізму та 1 отруєння грибами вдома.
Про це повідомляє Держпродспоживслужба області.
"Гострий гастроентерит зафіксували серед учнів загальноосвітньої школи №28 м.Житомира та 3 спалахи сальмонельозу на об’єктах ресторанного господарства та торгівлі", – повідомляють у службі.
Зокрема, отруїлися продуктами харчування у кафе:
· «Маячок» – с.Старий Любар Любарського району
· «Магнат» – с.Соснівка Олевського району
· «Вікторія» – с.Гальчин Андрушівського району (під час поминального обіду)
Головними причинами спалахів стали порушення санітарно-гігієнічного режиму, а також недотримання правил особистої гігієни працівниками харчоблоку (у ЗОШ №28). У кафе отруїлися через порушення технології приготування страв, правил зберігання сирої та готової продукції, умов миття кухонного та столового посуду, відсутність відповідної документації на продовольчу сировину.